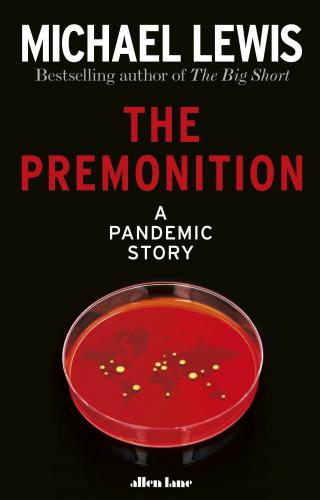

The Premonition A Pandemic Story
From the global bestselling author of The Big Short, the gripping story of the maverick scientists who hunted down Covid-19
'It's a foreboding,' she said. 'A knowing that something is looming around the corner. Like how when the seasons change you can smell Fall in the air right before the leaves change and the wind turns cold.'
In January 2020, as people started dying from a new virus in Wuhan, China, few really understood the magnitude of what was happening. Except, that is, a small group of scientific misfits who in their different ways had been obsessed all their lives with how viruses spread and replicated - and with why the governments and the institutions that were supposed to look after us, kept making the same mistakes time and again.
This group saw what nobody else did. A pandemic was coming. We weren't prepared.
The Premonition is the extraordinary story of a group who anticipated, traced and hunted the coronavirus; who understood the need to think differently, to learn from history, to question everything; and to do all of this fast, in order to act, to save lives, communities, society itself. It's a story about the workings of the human mind; about the failures and triumphs of human judgement and imagination. It's the story of how we got to now.
Trading Hours

We are instore for click and collect
MON - FRI: 9AM - 5.30PM
SAT: 9AM-6PM
SUN: 10AM-5PM
Location & Parking
- There is ample parking (90 minutes free) with an entry via St Andrews St.
- Dogs are welcome!
Contact Details

Shop 3 Dendy Plaza
26 Church St
Brighton, Victoria, 3186
PH: (03) 9553 8033
Email: enquiries@toptitles.com.au
Instagram: https://www.instagram.com/toptitles/
.png)
